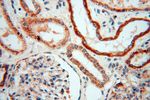
USMG5 Antibody in Immunohistochemistry (Paraffin) (IHC (P))

Search
Proteintech
USMG5 Polyclonal Antibody
{{$productOrderCtrl.translations['antibody.pdp.commerceCard.promotion.promotions']}}
{{$productOrderCtrl.translations['antibody.pdp.commerceCard.promotion.viewpromo']}}
{{$productOrderCtrl.translations['antibody.pdp.commerceCard.promotion.promocode']}}: {{promo.promoCode}} {{promo.promoTitle}} {{promo.promoDescription}}. {{$productOrderCtrl.translations['antibody.pdp.commerceCard.promotion.learnmore']}}
产品信息
17716-1-AP
种属反应
已发表种属
宿主/亚型
分类
类型
抗原
偶联物
形式
浓度
规格
纯化类型
保存液
内含物
保存条件
运输条件
产品详细信息
Immunogen sequence: MAGPESDAQ YQFTGIKKYF NSYTLTGRMN CVLATYGSIA LIVLYFKLRS KKTPAVKAT (1-58 aa encoded by BC072683)
靶标信息
Plays a critical role in maintaining the ATP synthase population in mitochondria. Target protein is a novel protein that is upregulated in streptozotocin-induced diabetic rats.
仅用于科研。不用于诊断过程。未经明确授权不得转售。
生物信息学
蛋白别名: ATP synthase F(0) complex subunit k, mitochondrial; ATP synthase membrane subunit DAPIT, mitochondrial; Diabetes Associated Protein in Insulin-sensitive Tissues; Diabetes-associated protein in insulin-sensitive tissues; HCV F-transactivated protein 2; HCVFTP2; unnamed protein product; up-regulated during skeletal muscle growth 5 homolog; Up-regulated during skeletal muscle growth protein 5; upregulated during skeletal muscle growth 5; upregulated during skeletal muscle growth 5 homolog
基因别名: 2010301L15Rik; AGP; ATP5MD; ATP5MK; bA792D24.4; DAPIT; HCVFTP2; MC5DN6; PD04912; USMG5
UniProt ID: (Human) Q96IX5, (Rat) Q9JJW3, (Mouse) Q78IK2
Entrez Gene ID: (Human) 84833, (Rat) 171069, (Mouse) 66477